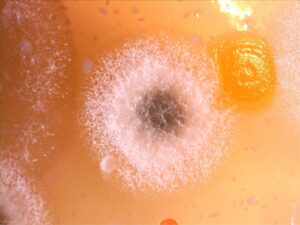

لمياء ابوالخير
كان سلطان يجلس في المطبخ يتأمل قطعة خبز نسيها على الطاولة منذ أيام.
اقترب منها بحذر وقال متعجبا:
غريب! لماذا أصبح لونها أخضر ومليئًا بالوبر؟
سمع صوتا صغيرا مألوفا، فإذا بصديقته النملة جميلة تخرج من خلف وعاء السكر وهي تبتسم:
-لا تقلق يا سلطان، ما تراه هذا من علامات خضراء على الخبز يسمى العفن.
فتح سلطان عينيه بدهشة:
-العفن؟ وما هو العفن، هل هو نبات؟
ضحكت جملية وقالت:
– لا لا، العفن ليس نباتا، إنه كائن صغير جدا يُسمّى فطر، لا نستطيع رؤيته إلا عندما يتجمع.
جلس سلطان على الكرسي وهو يصغي باهتمام:
– وكيف جاء إلى الخبز؟ أنا لم أضعه هناك!
أشارت جميلة إلى الهواء قائلة:
– جراثيم العفن هي جراثيم فطرية موجودة في الهواء في كل مكان. عندما تجد البيئة مناسبة، مع بعض الرطوبة والدفء، تبدأ في النمو.
اقترب سلطان قليلا وقال بقلق:
– هل هذا يعني أن الطعام فسد؟
هزت جميلة رأسها:
– نعم، العفن يتغذى على الطعام، فيتغير لونه وطعمه ورائحته.
سأل سلطان بسرعة:
– وهل هذا غير صحي؟
أجابت النملة بجدية:
– نعم..على الأغلب، إذا أكلنا طعاما متعفنا قد نمرض أو نشعر بألم في المعدة، ولكن الصناعة تستفيد من هذة العملية في صناعة بعض انواع الجبن فيما يعرف “بالتخمير”.
تكاثر العفن ليس أمرا ضار دائمًا، بل بالعكس، الآن تعتمد عليها صناعات بأكملها..تكمل جميلة حديثها، ومنها الصناعات التي تقوم على التخمير مثل الجبن، والخبز، والزبادي.
سأل سلطان:
– ولكن كيف يحدث ذلك، وهل تناولنا هذة الأطعمة من قبل؟
أجابت جميلة نعم يا عزيزي دعني اشرح لك.

فوائد العفن في الصناعات الغذائية:
هل تعلم يا سلطان أن فريق علمي من جامعة القاهرة-مصر- وجامعة كاتنيا- ايطاليا- عثرا على قطعة جبن عمرها حوالي 3200 عام داخل مقبرة مصرية. نشرت النتائج في تقرير تابع لمجلة الكيمياء التحليلية بتاريخ 18/ أغسطس في عام 2018.
سلطان بإندهاش: هل هذا صحيح يا جميلة؟
نعم يا عزيزي، على ما يبدو أن هذة الانواع من الجبن تعد لذيذة للغاية، وتلقي استحسانا لكثير منا، إذ تعتمد صناعة الجبن في جوهرها على مكونين أساسيين: الحليب، والمادة المُخثرة وبأختلاف الثقافات يختلف طعم الجبن من حيث التوابل والمنكهات.
صورة لفطر العفن تحت الميكروسكوب (ويكيميديا كومنز)
سلطان: ولكن كيف يحدث ذلك يا جميلة؟
جميلة: من خلال اضافة العديد من العناصر التالية مثل (فطريات نافعة، انزيمات، والحليب) مع مراعاة ظروف البيئة الازمة للاستزراع الصحيح، ومنها ينتج الكثير من انواع الجبن اللذيذة.
سلطان: الان هل صناعات الخبز والزبادي تنتمي لنفس الصناعات؟
جميلة: نعم يا عزيزي ولكن الفطريات الازمة لصناعة الخبز أو اللبن الزبادي تعد من الفطريات وحيده الخلايا على عكس التي تدخل في صناعة الجبن وهي الفطريات متعددة الخلايا، ولكن اللطيف يا سلطان أن جميعها ينتمي لنفس المملكة (مملكة الفطريات).

تحدث عملية التخمير في صناعة الخبز من خلال استهلاك الخميرة للسكريات البسيطة وتطلق الكحول وثاني أكسيد الكربون وتكون فقاعات مما يجعل الخبز رقيقًا وهشا ولذيذا.
سلطان: ولكن لماذا يحدث التعفن؟
جميلة: العفن يساعد الطبيعة على تنظيف نفسها، فهو يُحلل بقايا النباتات والطعام ويعيدها إلى التربة.
تداركت جميلة الاجابة وقالت: ولكن لا تستنشق هذا العفن، على الاغلب سوف يسبب لك بعض المشاكل التنفسية والحساسية، فلابد أن نحرص على تجنب تكاثر العفن في منازلنا لتجنب الاصابة بالامراض التنفسية والربو.

نصائح يا أصدقاء:
لابد أن نقلل نسبة الرطوبة الداخلية من (30-60)% للحد من نمو العفن من خلال:
- ينمو العفن في البيئات التي تكون فيها الرطوبة عالية، وعليه فمن الضرورري التحكم فيها من خلال انظمة التهوية والتكيف لازالة الرطوبة من الهواء.
- لا تضع السجاد على في المناطق التي توجد فيها مشكلة رطوبة دائمة (الاحواض، النوافير، الحمامات).
- ضع أنظمة تهوية في اماكن الطهي والتظيف و الحرص على تجفيف الاثاث في حال ظهور العفن عليها.
رد سلطان بثقة: الآن فهمت! العفن كائن له دور كبير في حياتنا الطبيعية.
قالت النملة وهي تعود إلى مخبئها:
وأنت اليوم أصبحت عالمًا صغيرا يا سلطان!
ابتسم سلطان ونظر إلى الخبز المتعفن وقال:
وداعا أيها العفن… شكرا لأنك علمتني درسا جديدا اليوم!

- نشاط لتجربة عملية في المنزل:
- كيف تُنتج الخميرة غاز ثاني أكسيد الكربون؟
الفرضية: إذا أضفنا الخميرة إلى ماء دافئ مع قليل من السكر، فإن الخميرة ستنشط وتنتج غاز ثاني أكسيد الكربون (الفقاعات).
الأدوات:
- ملعقة صغيرة خميرة جافة
- كوب ماء دافئ (ليس ساخنًا)
- ملعقة صغيرة سكر
- زجاجة أو كوب شفاف
- بالون صغير
الخطوات العملية:
- نضع الماء الدافئ في الزجاجة أو الكوب.
- نضيف السكر ونحرك جيدا حتى يذوب.
- نضيف الخميرة وننتظر دقيقة دون تحريك.
- نثبت البالون على فوهة الزجاجة.
- نترك الزجاجة في مكان دافئ ونراقب ما يحدث.
بعد عدة دقائق، نلاحظ:
- ظهور فقاعات داخل الماء.
- انتفاخ البالون تدريجيا.
الاستنتاج:
الخميرة كائن حي دقيق، وعند توفر الماء الدافئ والسكر:
- تتغذى الخميرة على السكر.
- وتنتج غاز ثاني أكسيد الكربون
- هذا الغاز هو سبب انتفاخ البالون.
المحاذير (اجراءات السلامة):
- يجب أن يكون الماء دافئًا فقط وليس ساخنًا
- عدم تذوق الخليط
- غسل اليدين بعد التجربة
- تنفيذ التجربة تحت إشراف شخص بالغ
تطبيق هذة النظرية في حياتنا اليومية:
- صناعة الخبز: الغاز يجعل العجين ينتفخ ويصبح هشا.
- صناعة الحلويات: يساعد على رفع العجين.
- العلوم الحيوية: فهم تنفس الكائنات الدقيقة.
- هذا النشاط مناسب لعمر 6-8 سنوات.